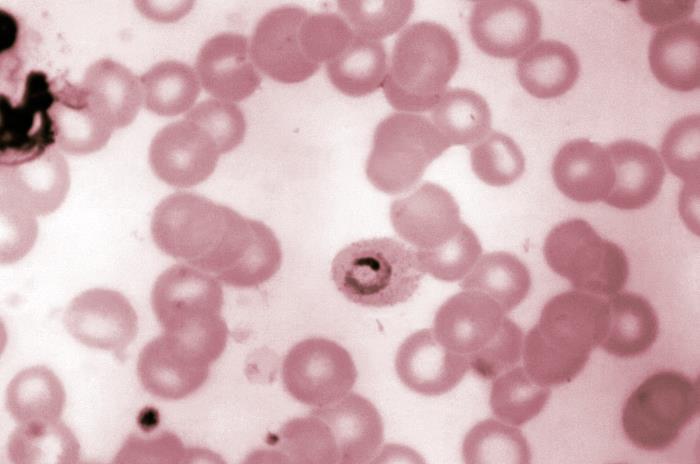

炎症并不常见。它与心脏病、糖尿病、癌症和自身免疫性疾病有关。但一项新的研究可能发现了人体对刺激物的自然反应的积极用途。研究人员发现,炎症会导致血浆成分发生变化,从而减缓导致疟疾的寄生虫的生长。他们希望自己的发现有朝一日能用于控制甚至预防这种疾病。

疟疾感染呈周期性发展。被感染了疟原虫的蚊子叮咬后,寄生虫首先以孢子虫的形式感染肝细胞,成熟后变成裂殖子,裂殖子破裂后释放出称为裂殖子的子代寄生虫。然后,子代虫感染红细胞,从滋养体成熟为裂殖体,裂殖体破裂并释放出子代虫,子代虫通过入侵其他红细胞继续循环。
墨尔本多尔蒂研究所(Doherty Institute)和悉尼柯比研究所(Kirby Institute)的研究人员领导的研究小组利用小鼠模型发现,当免疫系统引发炎症时,它会改变血浆的化学成分,产生抑制因子,直接损害疟原虫在红细胞滋养体阶段的成熟。
"首先,我们发现体内的炎症阻碍了寄生虫早期阶段的成熟,"该研究的通讯作者阿什拉福尔-哈克(Ashraful Haque)说。"我们还注意到,炎症引发了血浆成分的显著变化--实际上,我们对这些变化的幅度感到非常惊讶。随着我们的深入研究,我们在发生变化的血浆中发现了一些物质,我们认为这些物质可能会抑制寄生虫在体内的生长。"
通过基因组测序,研究人员发现,在改变后的血浆中循环四小时后,滋养体调整了它们的基因和蛋白质活性,导致成熟速度减慢。
该研究的合著者大卫-库里(David Khoury)说:"寄生在红细胞中的寄生虫能迅速感知新环境并做出反应,显示出惊人的适应能力。我们利用最先进的基因组测序技术观察到,即使在这种变化的血浆中仅仅呆了四个小时,寄生虫就调整了它们的基因和蛋白质活性,导致红细胞内的成熟速度减慢。这几乎就像是寄生虫主动感知到宿主环境的不友好,并因此触发了一种应对机制。"
研究人员说,这项研究的发现提出了一种可以减缓疾病发展的机制,这将带来潜在的益处。
"这项研究虽然基于动物模型,但拓宽了我们对疟疾的认识,"共同作者迈尔斯-达文波特(Miles Davenport)说。"它为进一步研究炎症调节寄生虫成熟所涉及的具体机制奠定了基础,并为未来研究探索已确定的抑制因子、遗传变化及其对疟疾发展的影响开辟了途径。最终,我们的工作旨在有朝一日为开发潜在的新战略提供信息,以控制、预防和减轻影响全球超过 2.4 亿人的疟疾负担。"
目前这项研究的发布非常及时。在过去几个月里,美国佛罗里达州和得克萨斯州报告了 8 例疟疾病例,这是自 2003 年以来首次在当地发现的病例。卫生专家认为,疟疾复发的原因是气候变化加剧以及 COVID-19 限制放宽后国际旅行增多,并敦促卫生专业人员提高警惕。疟疾如果不及时治疗会导致严重的健康问题,如癫痫发作、脑损伤、呼吸困难、器官衰竭和死亡。
这项研究发表在《mBio》杂志上。